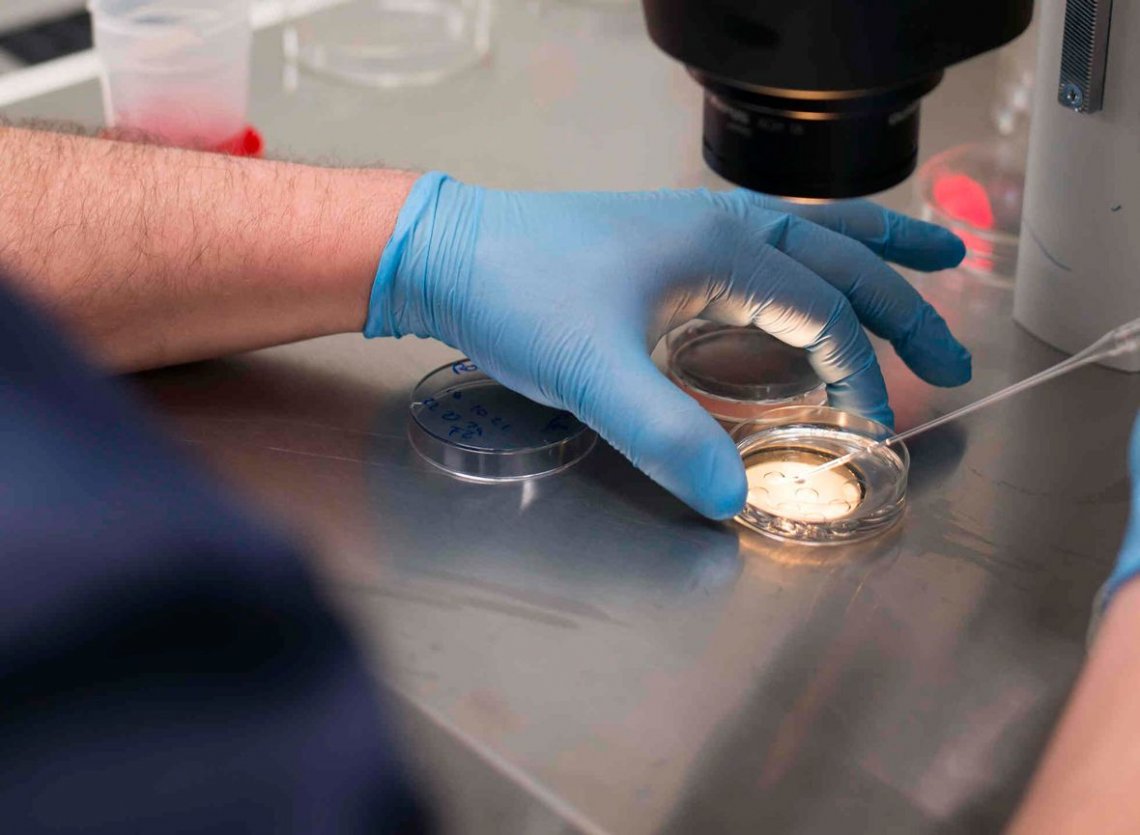

Células madre, un camino a la curación
La compatibilidad inmunológica a la hora de realizar un tratamiento de ovodonación, la cura de enfermedades a través de la edición genética embrionaria y el rejuvenecimiento ovárico son algunos de los temas que hoy están en boga en el campo de la medicina reproductiva. Aquí las explicaciones para comprender por qué se puede tener esperanzas..
Hace casi 40 años el mundo se revolucionaba tras la noticia del nacimiento de Louise Brown, la primera niña nacida gracias al tratamiento de Fecundación In Vitro. Actualmente es un tratamiento que se realiza diariamente y gracias al cual han nacido miles de niños a nivel mundial.
Pero la ciencia siempre nos sorprende con sus avances y nos acerca cada vez más a un mundo que antes era pensado como de ciencia ficción. La cura de enfermedades a través de la edición genética embrionaria, el rejuvenecimiento ovárico y la compatibilidad inmunológica a la hora de realizar un tratamiento de ovodonación son algunos de los temas que hoy están en boga en el campo de la Medicina Reproductiva.
Las enfermedades monogénicas son anomalías genéticas causadas por un fallo o mutación en un único gen. Ejemplos conocidos de este tipo de enfermedades son la Fibrosis Quística y la Hemofilia, entre otras.
“¿Qué sucede con los embriones que presentan este tipo de enfermedades? Es una pregunta que me hacen a diario los pacientes. En la actualidad los embriones que tienen este tipo de alteraciones son criopreservados y almacenados, pero gracias a los avances científicos que se fueron presentando en los últimos años, sabemos que en un futuro vamos a poder eliminar la enfermedad y obtener un embrión sano listo para implantar en el útero de la mujer”, afirma el doctor Fernando Neuspiller, director de IVI Buenos Aires.
El doctor Juan Carlos Izpisúa Belmonte, investigador de Salk Institute for Biological Studies y su equipo han avanzado en la utilización de esta herramienta en ratones por la cual son capaces de alterar los genes, tanto dentro de las células madre como in vivo, lo que potencialmente permite a los investigadores crear células “corregidas” dirigidas o redireccionada al tejido que se busca reparar.
Es decir, las células se podrían trasplantar a un paciente para curar la enfermedad hereditaria.
“Si bien hoy esta técnica se encuentra en una fase inicial de investigación, cuando se extienda a los seres humanos tendrá el potencial de prevenir que los recién nacidos hereden enfermedades monogénicas”, explicó el Dr. Neuspiller.
El uso de las células madre ha encontrado su lugar en la medicina reproductiva ayudando a revertir la infertilidad en mujeres que presentan enfermedades que disminuyen notablemente su probabilidad de embarazo.
En el caso del Síndrome de Asherman, una afección uterina debido a la cual las pacientes sufren de adherencias y cicatrices en el interior del útero; la Atrofia Endometrial, una patología del útero que impide que el endometrio consiga el grosor necesario para concebir y el fallo ovárico precoz, presente en el 10% de las mujeres.
“Las Células Madres Somáticas (CMS), que se encuentran en la capa basal del endometrio y serían las responsables de mantener su correcto funcionamiento ofrecen un prometedor poder terapéutico ya que se utilizarían con el fin de regenerar el endometrio en estas patologías”, cuenta.